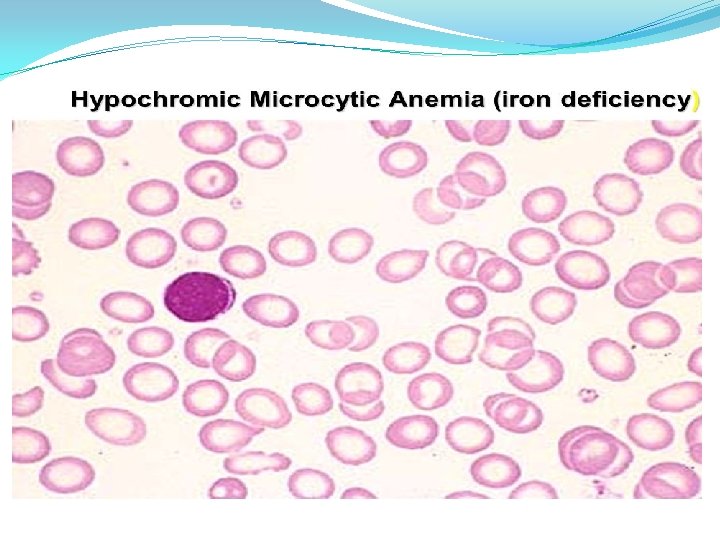
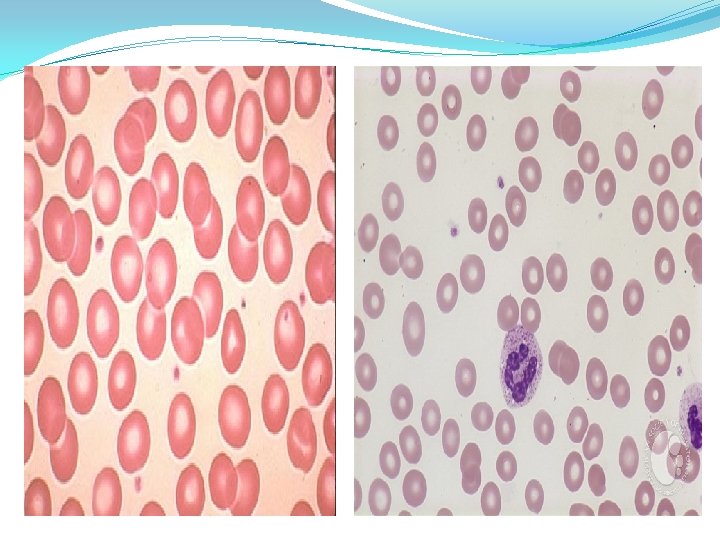

Anemia IRON DEFICIECY ANAEMIA Definition Microcytic anemia caused

- Slides: 18
Anemia
IRON DEFICIECY ANAEMIA Definition: Microcytic anemia caused by iron def. for any reason Iron physiology and metabolism: - normal diet provides =15 mg of iron /day. - 5 -10% is absorbed in duod. And upper jejunum. - total body iron stores = 4 gms. - around 1 mg is lost daily in urine, faeces, … - menstrual losses(20 mg/m), pregnancy(500 -1000 mg).
Etiological Factors q. Impaired iron absorption : Ø Achlorhydria. ØPlummer- Vinson syndrome. ØGastric surgery. Ø Ciliac dis. Ø pica. q Increased iron demands or loss. > chronic bleeding ( GIT , menses , urinary , etc. ) infancy Ø pregnancy. Ø lactation. Ø q Nutritional. q Idiopathic
Evaluation of patient: 1 - History : - H/O symptoms of anemia. - H/O blood loss GIT , menses , ……. . - Drug history NSAIDS. - past history of gastric surgery. - Diet history. - pica. 2 - Examination : - pallor , vital signs. - abdominal exam. - P. R. exam. - gynecological exam.
Diagnosis: - CBC: HB , - PBF : M. H. A , anisocytosis , poiklocytosis , tear drop cells. - S. iron (( )) RBCS indices (( MCV , MCHC)). , TIBC (( )) . - S. ferritin (( )). - Stool for occult blood ? ! - U/S of abdomen , pelvis. - B. M. A (( iron staining )) infrequently needed. - Endoscopy
Tear drop cells
Epidemiology : - IDA is the most common nutritional deficiency in developing and developed countries. - IDA is considered to be the leading cause of anemia worldwide , it accounting for as many as 50% of anemic cases. - Prevalence of IDA greatly varies according to : Age Gender , Physiological , Pathological , Enviromental and Socioeconomic conditions.
Peripheral smear Bone marrow iron Hypochromic & Miciocyhic Anaemia ABSENT INCREASED Ringed sideroblasts Hemoglobin electrophoresis Diagnosis Normal Abnormal Normal Iron def. anemie Thalassemia Sideroblastic anemia
Treatment: Ι- Oral replacement: Fe. Sulphate, gluconate, fumarate 150 -200 mg /day for six months. П- Parenteral replacment either IM or IV (( T. D. indicated for pts who are not tolerating oral iron, poor compliance and for rapid replacement pregnancy )) Pts planned for surgery , cases with malabsorption diseases.
Response to replacement: within 3 weeks the HB level will be increased with MCV and reticulocytosis. in after 3 months of treatment the MCV will be normal and HB normal.
Failure of response Revise the diagnosis (( Thalassemia )) Think of additional complications – ch. infection , C. T. D , malignancy. Patient compliance. Persistance of excessive blood loss. Associated other deficiency ((V 1 t. B 12 - folate )).
NORMOCYTIC NORMOCHROMIC ANEMIA Anemia of chronic disease ACD Causes : - Associated with connective tissue diseases. - Hematological disease, Aplastic anemia and MDS , MPD and acute leukemia. - Acute blood loss. - pregnancy and Renal failure. - Mixed deficiency of iron and folic or B 12.
Investigations: - CBC , PBF “ NN RBCs ‘’ , - S. ferritin : high N. - S. iron : N Low. - T. BIC : N Low. - Specific investigation according to the suspected cause , D/D of NNA: - chronic inflammatory diseases( infection, CTD, IBD ) - recent blood loss. - malignancy , marrow infiltration. - chronic renal failure. - marrow aplasia , hypoplasia. - HIV infection. - early nutritional anemia ( iron , B 12 , folate ).
�TREATMENT : * Treat the underlying cause. * Blood transfusion. * Erythropoietin. * iron , folic , B 12 supplement. TTT